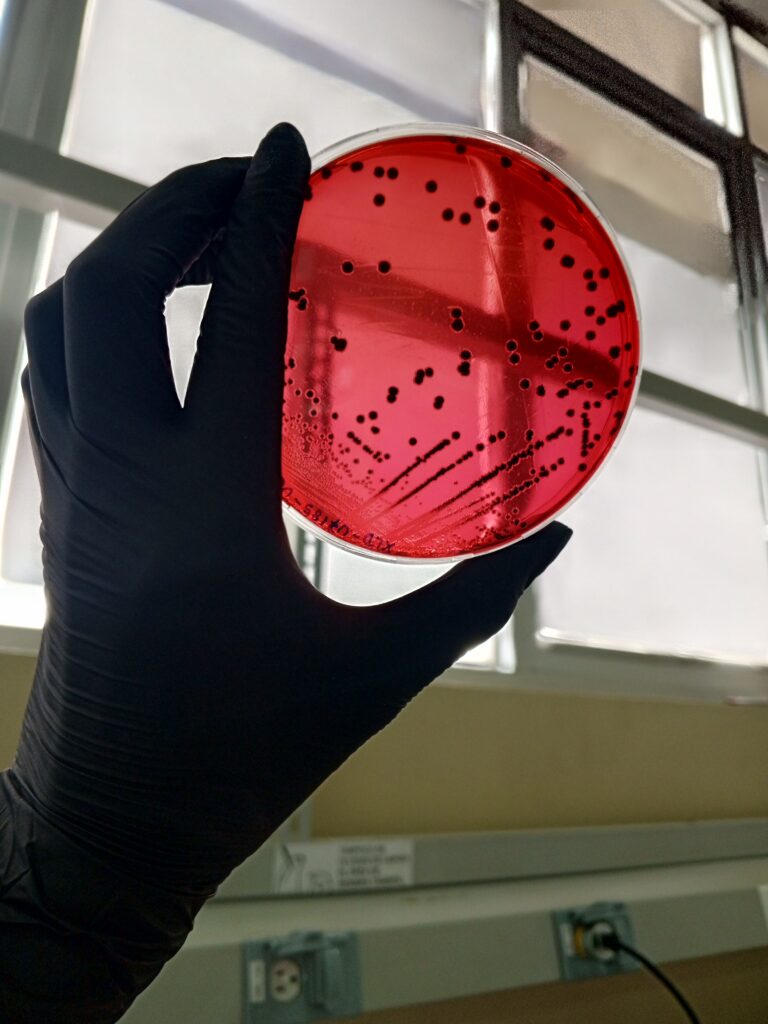
IMG_20250514_124158_113

Our research group at the Technical University of Ambato (Ecuador) focuses on microbial genomics, bioinformatics, and antimicrobial resistance (AMR) within a One Health framework. We investigate the genetic basis and ecological drivers of AMR across clinical, agricultural, and environmental settings, applying cutting-edge sequencing technologies (Oxford Nanopore, Illumina) and multi-omics approaches to understand and control the spread of high-priority pathogens.
Key projects include the creation of the first phage biobank in Ecuador targeting Salmonella enterica for poultry applications, multi-omics surveillance of AMR, and the characterization of microbial communities in polluted environments such as water bodies, sediments, hydrocarbons, and microplastics.
Our mission is to integrate genomic science, systems biology, and biotechnology to deliver innovative solutions for public health, sustainable food systems, and environmental resilience.
Follow us on social media!